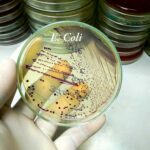

Chinese Researcher Smuggled E. coli: Security Threat
A Chinese researcher's alleged smuggling of E. coli strains into the U.S. threatens national security and agricultural stability.
Story Snapshot
Chinese researcher Youhuang Xiang charged...
$500 Million Oil Loophole Exposed in Venezuela
President Trump has launched an aggressive "blockade" targeting Venezuela's shadow tanker fleet, cutting off the socialist regime's primary revenue lifeline.
Story Highlights
Trump orders blockade...
First-Ever UUV Attack on Russian Submarine
Ukraine's underwater drone strike on a Russian submarine marks a historic shift, challenging naval power dynamics and impacting global security.
Story Snapshot
Ukraine executes the...
Missile Drone Threat Escalates Air War in Ukraine
A new missile-armed drone from Russia, packed with foreign-made parts, threatens to escalate the air war over Ukraine.
Story Highlights
Russia's new Shahed drone variant,...
Four Droughts Ended an Empire
Scientists have finally solved one of archaeology's greatest mysteries, revealing that the mighty Indus Valley Civilization didn't collapse from invasion or catastrophe.
Story Highlights
Four...
Moscow Aviation Paralyzed by Drone Swarm
Ukraine's unprecedented 300-drone assault on Moscow exposed critical vulnerabilities in Russian air defenses, forcing the complete shutdown of the capital's aviation hub.
Story Highlights
Nearly...
Fighter Jet Radar Lock Sparks Crisis
Chinese fighter jets locked fire control radar on Japanese F-15s over international waters, marking one of the most dangerous escalations in the region that...
Abu Shabab’s Assassination Threatens Fragile Gaza Peace Efforts.
Yasser Abu Shabab's assassination threatens the fragile peace efforts in Gaza, highlighting a perilous power vacuum.
Story Overview
Yasser Abu Shabab, a key anti-Hamas leader,...
New WHO Fertility Rule Sparks Family Value Crisis
A new guideline on infertility from the World Health Organization sparks debate over its inclusive approach to fertility care.
Story Highlights
The WHO's guideline on...
Bond-Inspired Jewel Awaits Natural Return
The bizarre theft of a $19,000 Fabergé pendant in New Zealand has raised eyebrows as law enforcement awaits its natural return.
Story Overview
A New...